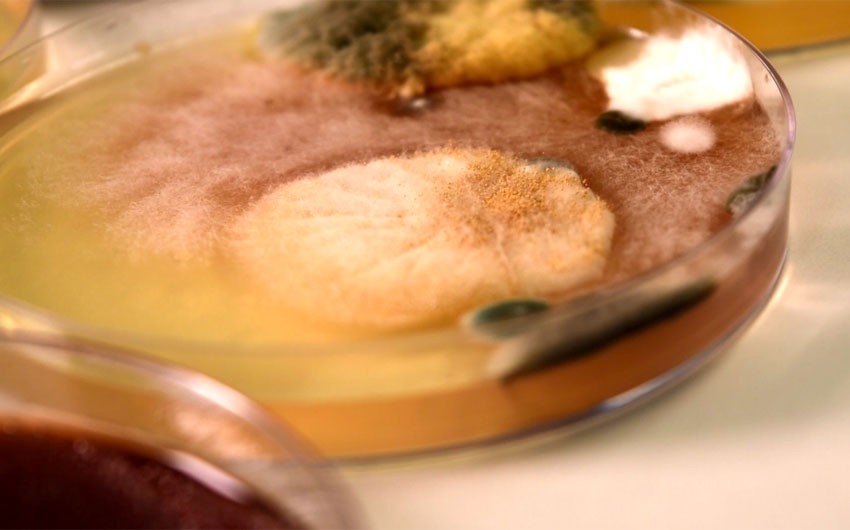

Geladeiras sem limpeza correta podem conter mais de 2 milhões de bactérias, aponta estudo de Campinas
Pesquisadora da área de microbiologia analisou 40 partes de geladeiras, incluindo porta-ovos, maçaneta, prateleiras, gavetas e borrachas de vedação. Contaminação pode causar infecções e micoses. Fungos variados encontrados dentro de uma geladeira doméstica durante pesquisa de universidade de Campinas. Patrícia Teixeira/G1 Com que frequência você limpa a sua geladeira? E os ovos? Costuma lavar antes de arrumar na bandeja? Uma pesquisa da Faculdade de Biomedicina da UniMetrocamp, em Campinas (SP), analisou 40 partes de geladeiras e constatou a presença de mais de 2 milhões de bactérias, além de mais de 44 mil bolores e leveduras. E não se engane pensando que as baixas temperaturas desse ambiente afastam os riscos para a saúde. "A baixa temperatura só deixa o micro-organismo mais lento. A bactéria vai crescer, mas lentamente. Isso não quer dizer que ela vai estar morta. Ela vai estar bem viva naquele ambiente", afirma a doutora em ciências de alimentos e coordenadora do estudo, Rosana Siqueira. Além dos 8 porta-ovos, foram analisadas amostras coletadas de 8 maçanetas, 8 gavetas, 8 prateleiras e 8 borrachas de vedação. Todas as geladeiras do estudo são domésticas. Veja detalhes do estudo e dicas de higienização no vídeo, abaixo. Pesquisa da UniMetrocamp encontra mais de 2 milhões de bactérias em geladeiras domésticas Os resultados de uma higiene incorreta vão desde micoses até infecções intestinais, urinárias, de garganta, febre e otite. "O resultado surpreendeu, principalmente porque as bactérias e os fungos podem acabar contaminando os alimentos que estão limpos na geladeira", afirma a pesquisadora. Fungos e bactérias foram encontrados em 40 partes de geladeiras, em pesquisa de Campinas. Patrícia Teixeira/G1 Entre os micro-organismos identificados por Rosana e as alunas Amanda Guidotti e Luiza Rached no trabalho de conclusão do curso de Biomedicina estão as bactérias E. coli, S. aureus, K. pneumoniae, Acinetobacter e os fungos Candida albicans e C. krusei. "Em 24 horas cresceram as bactérias e em até cinco dias cresceram os fungos. Surpreendeu. A gente não imaginava que iam crescer tantos tipos de bactérias e fungos", diz Luiza. "Nas placas [de laboratório], as colônias crescem. Na geladeira, elas são invisíveis, mas basta só um pouquinho desse micro-organismo no alimento para a pessoa desenvolver algum problema de saúde", explica Amanda. Amanda Guidotti e Luiza Rached, alunas de Biomedicina da UniMetrocamp que realizaram a pesquisa de contaminação nas geladeiras em Campinas. Patrícia Teixeira/G1 Veja a quantidade máxima de micro-organismos encontrados em uma única unidade dos itens analisados: Maçanetas - 310 mil bactérias e 3,3 mil bolores e leveduras Prateleiras - 520 mil bactérias e 15 mil bolores e leveduras Porta-ovos - 270 mil bactérias e 3,8 mil bolores e leveduras Gavetas - 610 mil bactérias e 21 mil bolores e leveduras Borrachas de vedação - 420 mil bactérias e 1,6 mil bolores e leveduras A gaveta chamou a atenção no estudo, e a pesquisadora explica que é porque ela fica fechada e, às vezes, úmida. Isso favorece o desenvolvimento dos micro-organismos, assim como deixar a geladeira aberta por muito tempo. "A quantidade que nós encontramos é suficiente para causar um desconforto numa pessoa considerada saudável. Em uma pessoa com o sistema imunológico já debilitado, essa quantidade pode ser preocupante. Principalmente crianças, idosos, ou pessoas que tenham uma enfermidade", explica Rosana. Doutora em Ciência de Alimentos e coordenadora da pesquisa de Campinas sobre contaminação em geladeiras, Rosana Siqueira faz a contagem de bactérias encontradas. Patrícia Teixeira/G1 Origem da contaminação A atenção para evitar a contaminação começa nas sacolinhas de supermercado, passa pelas sujeiras presentes nos produtos - e vai até as mãos do consumidor, que muitas vezes acessa a geladeira sem antes fazer uma higienização com água e sabão. "É o que nós chamamos de contaminação cruzada. As bactérias do dinheiro acabam ficando nas mãos da pessoa e, com as mãos, ela pega o alimento. Quando a pessoa o leva para a sua casa, leva também os micro-organismos junto", diz a coordenadora do estudo. "Lavar o ovo antes de manipular, porque a contaminação que fica na casquinha do ovo também passa para as mãos", orienta Rosana. Amostra colhida em parte da geladeira é analisada no laboratório da Faculdade de Biomedicina da UniMetrocamp, em Campinas. Patrícia Teixeira/G1 Aprenda a higienizar a geladeira As pesquisadoras orientam que a limpeza da geladeira deve ser feita no dia a dia, sem deixar acumular muita sujeira. Basta água e detergente ou sabão neutro para retirar restos de alimentos, por exemplo. As paredes também precisam de atenção na hora da higienização. "A limpeza, é fundamental ser de cima para baixo. É fundamental também a higienização das maçanetas, porque a gente entra muito em contato, com as nossas mãos. E também a borracha", ensina a coordenadora. Rosana Siqueira recomenda o uso de água quente, pois os micro-organismos não resistem a altas temperaturas, e deixar secar bem as partes removíveis da geladeira antes de recolocá-las nas suas posições. A pesquisadora Rosana Siqueira, de Campinas, mostra como a geladeira deve ser higienizada para evitar contaminação por fungos e bactérias. Patrícia Teixeira/G1 O cheiro da geladeira também merece atenção especial. O odor que o consumidor sente já pode ser um indicativo de que há algo estragado na geladeira. Bolores e leveduras têm cheiro forte. "Basta usar um pouco de bicarbonato diluído em água na geladeira ou vinagre diluído para remover o cheiro. Também pode deixar um potinho com bicarbonato na porta da geladeira", explica a coordenadora. Mesmo com a manutenção no dia a dia, uma faxina mais completa e precisa deve ser feita uma vez a cada um ou dois meses, orientam as pesquisadoras. "A maior parte das intoxicações e infecções que nós temos vem da nossa própria casa, e às vezes a gente acha que foi de um alimento que a gente comeu fora. Essa quantidade de micro-organismos dentro da nossa casa é preocupante", explica Rosana Siqueira. Bactérias, bolores e leveduras encontradas em geladeira doméstica analisada pela Faculdade de Biomedicina da UniMetrocamp, em Campinas. Patrícia Teixeira/G1 Veja mais notícias da região no G1 Campinas
Texto completo







